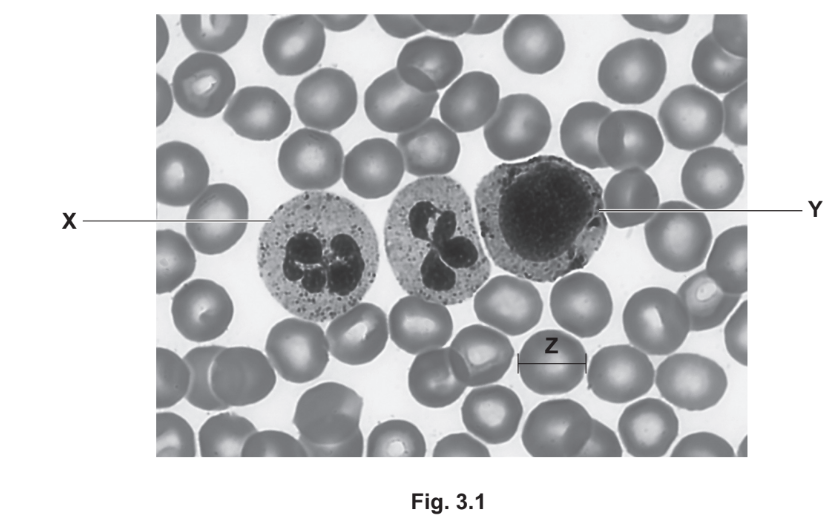
Blood cell photomicrograph

Topic: 5.1
The cells in a tissue are often at different stages of the cell cycle.
(a) Fig. 1.1 shows cells at different stages of the cell cycle.

(i) Identify the stages of mitosis occurring in the cells labelled B and C in Fig. 1.1.
(ii) Describe the behaviour of the chromosomes in the stage of mitosis shown in cell A in Fig. 1.1.
(iii) Cell D in Fig. 1.1 is in interphase.
Describe the role of DNA ligase in interphase.
(b) Telomerase is an enzyme that is active during interphase in some cells.
Telomerase helps to maintain telomeres present on chromosomes.
(i) State the location of telomeres on a chromosome.
(ii) Some people with a long lifespan have cells showing a higher than normal activity of telomerase.
Suggest why a long lifespan could result from a higher telomerase activity.
▶️ Answer/Explanation
(a)(i)
B: Prophase – Chromosomes condense and become visible, nuclear envelope starts to break down.
C: Metaphase – Chromosomes align at the cell’s equatorial plate.
(a)(ii) (Cell A shows anaphase)
1. Sister chromatids separate at centromeres
2. Spindle fibers pull chromatids to opposite poles
3. Chromosomes appear V-shaped as they’re pulled
4. Each chromatid now called a daughter chromosome
(a)(iii) DNA ligase in interphase:
• Joins Okazaki fragments on lagging strand during DNA replication
• Forms phosphodiester bonds between nucleotides
• Completes sugar-phosphate backbone
• Essential for DNA repair mechanisms
(b)(i) Telomeres are located at both ends of eukaryotic chromosomes.
(b)(ii) Higher telomerase activity may increase lifespan because:
1. Maintains telomere length over more cell divisions
2. Prevents premature cellular senescence
3. Allows more cell renewal cycles in tissues
4. Reduces loss of genetic information at chromosome ends
Topic: 11.1
The number of cases of tuberculosis (TB) is affected by many biological, social and economic factors.
(a) The number of reported cases of TB in the USA between 1980 and 2000 is shown in Fig. 2.1.

(i) Describe the trends shown in Fig. 2.1 between 1980 and 2000.
(ii) The number of reported cases of TB between 1984 and 1992 in the USA may have been affected by an increase in the number of people infected with HIV.
Explain how an increase in the number of people infected with HIV could have affected the number of TB cases.
(b) Mycobacterium tuberculosis is a species of bacterium that causes TB. Strains of M. tuberculosis have evolved resistance to some of the antibiotics used to treat the disease.
State two ways that the impact of antibiotic resistance can be reduced.
(c) TB can affect every part of the human gas exchange system, including the trachea, bronchi and alveoli.
(i) The cartilage in the bronchi can be damaged in some people with TB.
Suggest the effect that damage to cartilage may have on the bronchi.
(ii) Table 2.1 shows four types of cell and three structures found in the gas exchange system.
Complete Table 2.1 to show the distribution of cell types in each structure of the gas exchange system.

Use a tick (✓) if the cell type is present in the structure and a cross (✗) if the cell type is not present.
Put a tick (✓) or a cross (✗) in every box.
▶️ Answer/Explanation
2(a)(i)
1. Overall decrease from ~27,700 cases (1980) to ~16,400 cases (2000).
2. Initial decline (1980-1984), followed by an increase (1984-1992).
3. Steady decrease after 1992.
Explanation: The graph shows a long-term reduction in TB cases, with a temporary resurgence during the HIV epidemic (1984-1992) before renewed decline post-1992 due to improved healthcare interventions.
2(a)(ii)
HIV weakens the immune system by destroying CD4+ T-cells, making individuals more susceptible to TB infection and reactivation of latent TB.
Explanation: HIV compromises cell-mediated immunity, allowing Mycobacterium tuberculosis to proliferate unchecked. This synergy between HIV and TB led to increased transmission and case numbers during the peak of the AIDS epidemic.
2(b)
1. Strict antibiotic stewardship (only prescribing when necessary and ensuring complete courses).
2. Development of new antibiotics and alternative treatments.
Explanation: Rational antibiotic use prevents selection pressure for resistant strains, while research provides new therapeutic options against drug-resistant TB.
2(c)(i)
Bronchial collapse due to loss of structural support.
Explanation: Cartilage rings maintain bronchial patency; their destruction by TB leads to airway obstruction and impaired ventilation.
2(c)(ii)

Explanation: Ciliated cells and goblet cells are present in trachea/bronchi (for mucociliary clearance) but absent in alveoli. Squamous epithelium lines alveoli for gas exchange, while cartilage-supporting cells are exclusive to trachea/bronchi.
Topic: 8.1
Blood contains white blood cells and red blood cells.
(a) Fig. 3.1 is a photomicrograph showing different types of blood cell.
(i) Identify cell X and cell Y in Fig. 3.1.
(ii) The width of one of the cells in Fig. 3.1 is represented by the line Z. The actual width of cell Z is 8μm. Calculate the magnification used to produce the image shown in Fig. 3.1. Write down the formula you will use to make your calculation.

magnification = x ……………
(b) Carbonic anhydrase is an enzyme found in red blood cells.
(i) Describe how carbonic anhydrase is involved in the release of oxygen from red blood cells at respiring tissues.
(ii) Sulfonamide is a competitive inhibitor of carbonic anhydrase. Fig. 3.2 shows the effect of increasing substrate concentration on the rate of the reaction catalysed by carbonic anhydrase. Sketch a curve on Fig. 3.2 to show the effect of sulfonamide on the rate of reaction catalysed by carbonic anhydrase.

▶️ Answer/Explanation
(a)(i)
X: Neutrophil (identified by multi-lobed nucleus and granular cytoplasm)
Y: Monocyte (large kidney-shaped nucleus; may be confused with lymphocyte but is larger)
Explanation: Neutrophils are the most abundant white blood cells with distinctive lobed nuclei, while monocytes are larger with a characteristic U-shaped nucleus.
(a)(ii)
Formula: \(\text{magnification} = \frac{\text{image size}}{\text{actual size}}\)
Calculation: If line Z measures ~12 mm (12000 μm) in the image, and actual width is 8 μm:
\(\text{magnification} = \frac{12000\ \mu m}{8\ \mu m} = 1500\times\)
Explanation: The magnification is calculated by comparing the measured image size to the actual cell size. The answer may vary slightly depending on precise measurement of line Z.
(b)(i)
- Carbonic anhydrase catalyzes the reaction: \(CO_2 + H_2O \rightleftharpoons H_2CO_3\) (carbonic acid).
- Carbonic acid dissociates into \(H^+\) and \(HCO_3^-\) ions.
- \(H^+\) binds to hemoglobin, forming hemoglobinic acid, which reduces hemoglobin’s oxygen affinity (Bohr effect).
- This causes oxygen to be released to respiring tissues.
Explanation: The enzyme facilitates CO₂ transport and acid formation, which indirectly promotes oxygen unloading where it’s needed most.
(b)(ii)
The curve should show:
- A lower initial rate of reaction compared to the uninhibited curve.
- Gradual convergence with the original curve at high substrate concentrations (characteristic of competitive inhibition).

Note: A dashed curve below the original, merging at high [S], should be sketched.
Explanation: Sulfonamide competes with the substrate for the active site, reducing reaction rate at low [S]. At high [S], substrate outcompetes the inhibitor, restoring maximum velocity (Vmax remains unchanged).
Topic: 4.2
Food crops such as barley and wheat contain gluten. Gluten contains two proteins, glutenin and gliadin.
(a) (i) Table 4.1 contains descriptions of the structures of glutenin and gliadin.
Complete Table 4.1 by writing the level of protein structure that applies to each description.

(ii) Many genes in eukaryotic cells contain introns. The genes that code for gliadin do not contain introns.
Explain how a lack of introns in a gliadin gene affects the production of mRNA from the primary transcript.
(b) Coeliac disease is a condition in which the immune system of a person responds to gluten in their diet.
In coeliac disease, there is a response to the presence of peptides (short chains of amino acids) that are produced as a result of gliadin digestion.
(i) The gliadin peptides produced as result of digestion are often as large as 33 amino acids in length. Intestinal cells take up large numbers of these peptides at the same time.
Suggest and explain how gliadin peptides are transported into intestinal cells.
(ii) The presence of gliadin causes the immune system of a person with coeliac disease to respond by producing anti-gliadin antibodies.
Describe the sequence of events that results in the immune system producing anti-gliadin antibodies.
▶️ Answer/Explanation
(a)(i)

Explanation: The completed table shows that disulfide bonds between polypeptide chains represent quaternary structure, while α-helices and β-pleated sheets are secondary structure features.
(a)(ii) Since gliadin genes lack introns, no RNA splicing is needed – the primary transcript directly becomes mature mRNA.
Explanation: Without introns, the transcription process is simpler as the entire coding sequence is preserved without needing spliceosome activity to remove non-coding regions.
(b)(i) Gliadin peptides are transported via endocytosis, where the cell membrane invaginates to form vesicles containing the peptides.
Explanation: This bulk transport mechanism is energy-dependent (requires ATP) and allows uptake of large peptide fragments that can’t cross the membrane via simple diffusion.
(b)(ii) The immune response involves: antigen presentation → lymphocyte activation → clonal expansion → cytokine release → plasma cell differentiation → antibody production.
Explanation: Gliadin peptides are recognized as foreign antigens, triggering B-cells (with T-helper cell assistance) to proliferate and differentiate into antibody-secreting plasma cells.
Topic: 7.1
Phloem and xylem are specialised tissues involved in the transport of water, ions and assimilates in plants.
(a) A photomicrograph of a transverse section of a dicotyledonous stem is shown in Fig. 5.1.

Use label lines and labels to identify the phloem tissue and xylem tissue in Fig. 5.1. [2]
(b) (i) Describe how sucrose is transported in phloem sieve tubes from photosynthesising leaves to other parts of the plant.
(ii) Cyanide ions (CN–) inhibit the activity of an enzyme involved in respiration. Suggest why the treatment of photosynthesising leaves with CN– results in less sucrose being transported into phloem sieve tubes.
(c) A student was asked to carry out semi-quantitative Benedict’s tests on two solutions:
- Solution A was extracted from the cytoplasm of cells in the mesophyll tissue of photosynthesising leaves.
- Solution B was extracted from the phloem sap in phloem sieve tubes.
The solutions were taken from the same plant, and other variables were standardised. For each solution, the student measured the time taken for the first colour change to appear. Suggest which of the two solutions, A or B, would change colour in the shortest time. Explain your answer.
▶️ Answer/Explanation
(a)

Explanation: The phloem (sugar transport tissue) is typically located towards the outer part of vascular bundles, while xylem (water transport tissue) is found towards the inner part, identifiable by its larger vessels.
(b)(i)
Explanation: Sucrose transport occurs through mass flow:
- Sucrose is actively loaded into phloem sieve tubes from companion cells
- This lowers water potential, causing water to enter by osmosis from xylem
- Creates high hydrostatic pressure at source (leaves)
- Sucrose unloaded at sinks creates low pressure, driving flow from high to low pressure
(b)(ii)
Explanation: Cyanide inhibits cytochrome oxidase in aerobic respiration, leading to:
- Reduced ATP production → less energy for active transport of sucrose into phloem
- Impaired proton pump activity → decreased sucrose cotransport with H+ ions
- Resulting in less sucrose available for phloem loading
(c)
Explanation: Solution A (cytoplasm) would change color faster because:
- It contains reducing sugars (glucose) that react with Benedict’s solution
- Phloem sap (Solution B) primarily contains non-reducing sucrose which doesn’t react unless hydrolyzed first
- Benedict’s test detects reducing ends of monosaccharides but not disaccharides like sucrose
Topic: 2.2
Polysaccharides, such as glycogen, are composed of thousands of monomers.
Oligosaccharides are carbohydrates that contain three to ten monomers in their chain.
(a) Nystose is one example of an oligosaccharide. The structure of nystose is shown in Fig. 6.1.

State three differences between the structures of nystose and glycogen, other than the number of monomers in the molecules.
(b) Cells use oligosaccharides to synthesise glycoproteins, which are transported to cell surface membranes.
Describe the roles of the rough endoplasmic reticulum and the Golgi body in synthesising glycoproteins.
(c) State one role of glycoproteins in the cell surface membrane.
▶️ Answer/Explanation
(a) Three structural differences between nystose and glycogen:
- Branching: Glycogen is highly branched (with α-1,6 glycosidic bonds at branch points), while nystose is linear (only β-1,2 glycosidic bonds).
- Monomer composition: Nystose contains both glucose and fructose monomers, whereas glycogen consists solely of glucose.
- Ring structure: Nystose has five-membered (fructose) and six-membered (glucose) rings, while glycogen has only six-membered glucose rings.
Note: The number of monomers (nystose: 4; glycogen: thousands) is excluded as per the question.
(b) Roles of RER and Golgi in glycoprotein synthesis:
- Rough ER:
- Ribosomes on RER synthesize polypeptide chains via translation.
- Polypeptides are folded into tertiary structures in the ER lumen.
- Initial glycosylation (attachment of oligosaccharides) occurs here.
- Transport vesicles bud off to carry proteins to the Golgi.
- Golgi Body:
- Modifies oligosaccharide chains (e.g., trimming or adding sugars).
- Sorts glycoproteins into secretory vesicles for transport to the membrane.
- Quality control: Misfolded proteins are tagged for degradation.
(c) Role of glycoproteins in cell membranes:
Cell recognition/signaling: Glycoproteins act as receptors (e.g., for hormones) or antigens (e.g., ABO blood group markers).
Alternative answer: Facilitate cell-cell adhesion (e.g., in immune responses or tissue formation).
